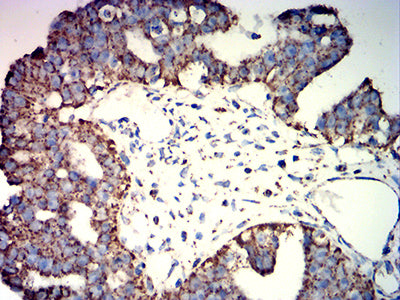

Mouse Monoclonal Antibody to ATP5F1A
Description |
|---|
This gene encodes a subunit of mitochondrial ATP synthase. Mitochondrial ATP synthase catalyzes ATP synthesis, using an electrochemical gradient of protons across the inner membrane during oxidative phosphorylation. ATP synthase is composed of two linked multi-subunit complexes: the soluble catalytic core, F1, and the membrane-spanning component, Fo, comprising the proton channel. The catalytic portion of mitochondrial ATP synthase consists of 5 different subunits (alpha, beta, gamma, delta, and epsilon) assembled with a stoichiometry of 3 alpha, 3 beta, and a single representative of the other 3. The proton channel consists of three main subunits (a, b, c). This gene encodes the alpha subunit of the catalytic core. Alternatively spliced transcript variants encoding the different isoforms have been identified. Pseudogenes of this gene are located on chromosomes 9, 2, and 16. |
References |
|---|
| 1.Oxid Med Cell Longev. 2018 Nov 14;2018:1347174. 2.Oncol Rep. 2018 Feb;39(2):525-536. |
Specification |
|
|---|---|
| Aliases | OMR; ORM; ATPM; MOM2; ATP5A; hATP1; ATP5A1; MC5DN4; ATP5AL2; COXPD22; HEL-S-123m |
| Entrez GeneID | 498 |
| Swissprot | P25705 |
| clone | 3A6B9 |
| WB Predicted band size | 59.8kDa |
| Host/Isotype | Mouse IgG1 |
| Antibody Type | Primary antibody |
| Storage | Store at 4°C short term. Aliquot and store at -20°C long term. Avoid freeze/thaw cycles. |
| Species Reactivity | Human, Mouse, Rat, Monkey |
| Immunogen | Purified recombinant fragment of human ATP5F1A (AA: 44-220) expressed in E. Coli. |
| Formulation | Purified antibody in PBS with 0.05% sodium azide |
Application |
|
|---|---|
| WB | 1/500 - 1/2000 |
| IHC | 1/200 - 1/1000 |
| FCM | 1/200 - 1/400 |
| ELISA | 1/10000 |
Product Image
-
Black line: Control Antigen (100 ng);Purple line: Antigen (10ng); Blue line: Antigen (50 ng); Red line:Antigen (100 ng)

-
Western blot analysis using ATP5F1A mouse mAb against COS7 (1), NIH/3T3 (2), mouse heart (3), rat heart (4), HCT116 (5), Hela (6), and HepG2 (7) cell lysate.

-
Flow cytometric analysis of Jurkat cells using ATP5F1A mouse mAb (green) and negative control (red).

-
Immunohistochemical analysis of paraffin-embedded human lung cancer tissues using ATP5F1A mouse mAb with DAB staining.

-
Immunohistochemical analysis of paraffin-embedded human ovarian cancer tissues using ATP5F1A mouse mAb with DAB staining.

鄂公网安备42018502007531号

